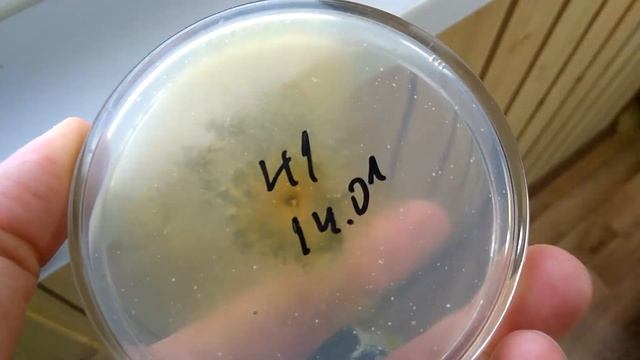
Разные триходермы и отличия триходермы от пеницилла смотреть онлайн

Автор / Канал: Секреты Продуктивного Творчества Страница 8

БРОШИ-ЗАЖИМЫ для шейного платка (часть 1) Beaded Swarovski

§21. Движение воды в океане

вклад или квартира для аренды куда выгоднее вложить детальный расчет

Снег идет и хрустит под ногами

Мастер класс по живописи Гладиолусы Автор Дубчак П В

Свадьба. Развод. Уклад жизни. БАЛИ

Что такое АЧХ динамика?

8.08.23-у нас Фарфоровая свадьба- 20 лет вместе! Прогулка по вечерней Набережной

05 Белковец. ТЕМА 5. ПРАВОВОЕ ПОЛОЖЕНИЕ НАСЕЛЕНИЯ МОСКОВСКОЙ РУСИ (XIV–XVII вв.)

Всемирно известная шуллерская игра "Три листа"

Православные отмечают сегодня один из главных церковных праздников

20 Спирт. Муравьиная, уксусная кистоты. Радикал. Стеарин

Учимся пользоваться компасом ПОХОД ЗА ГРИБАМИ по сибирским лесам

Основы написания барабанных партий в редакторе Guitar Pro

Двойной интеграл (часть 2). Геометрический смысл. Объем цилиндрического тела. Высшая математика.

?КАК СОЗДАТЬ ДС КРАШ БОТА?НА ТЕЛЕФОНЕ??

играем с ребенком. Макет города для детского сада тема ПДД и дорожные знаки

КОРОБКА КАНВЫ: выбор основы | зачем?
Разные триходермы и отличия триходермы от пеницилла

Десерт за пять минут

Cомбреро для игрушки (вязание крючком). 4 вариант / Crochet sombrero. Tutorial 4

КАК ПОСМОТРЕТЬ СВОИХ ПОДПИСЧИКОВ В 2023 ГОДУ | Как Узнать Кто Подписан На Тебя На Телефоне

How Google And Gmail Dominated Consumer Email

ПОЧИНИЛ ОКУ + ОТКРЫВАЮ ТЮНИНГ НА НИВУ | ПРОХОЖДЕНИЕ РЕТРО ГАРАЖ #30
За каждым успешным каналом стоит личность, идея и сотни часов кропотливого труда. Если вы здесь, значит, автор «Секреты Продуктивного Творчества» уже сумел зацепить ваше внимание своим уникальным стилем или подачей. А мы на RUVIDEO позаботились о том, чтобы вы могли изучить весь архив его работ в максимально комфортных условиях — без лишней суеты и преград.
Почему за работами канала «Секреты Продуктивного Творчества» так интересно наблюдать? Всё просто: это честный контент, который находит отклик в сердцах зрителей. На нашем ресурсе вы можете смотреть онлайн все видео любимого автора бесплатно и в хорошем качестве. Нам важно, чтобы вы видели каждую деталь и слышали каждый нюанс, поэтому мы используем только стабильные плееры из открытых источников Rutube.
Следите за новинками канала, пересматривайте старые шедевры и открывайте для себя новые грани творчества «Секреты Продуктивного Творчества». Мы постоянно обновляем ленту, чтобы у вас под рукой всегда были самые свежие выпуски. Никаких сложных регистраций — только вы и творчество, которое вдохновляет. Приятного вам путешествия по миру авторского контента на RUVIDEO!
Видео взято из открытых источников Rutube. Если вы правообладатель, обратитесь к первоисточнику.